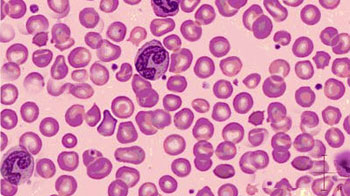
abbildung 1 33

Eisenmangel: Diagnostik
Bedeutung der Krankheitsgeschichte, Messung und Interpretation von Laborwerte
Anamnese
Unabhängig davon, ob ein Eisenmangel mit oder ohne Anämie besteht, muss der Ursache des Befundes nachgegangen werden. Die Befragung des Patienten ist ein zentrales Element in der Diagnostik:
- Besteht ein erhöhter Bedarf? - Wachstum, Schwangerschaft, Stillen, Abort, Spitzensport?
- Ist die Zufuhr vermindert? Fleisch- und Fischkonsum, Früchte?; Soja, Tee, Kaffee, Ballaststoffe als Hemmer der Eisenresorption?
- Ist die Eisenaufnahme gestört? Gewichtsabnahme, Blähungen, Durchfall, Familienanamnese, Operationen, Magen- oder Bauchschmerzen?
- Besteht ein übermässiger Verlust? Menorrhagie (mehr als 12 Binden pro Periode oder Dauer > 7 Tage), Blutspenden, rez. Nasenbluten, Meläna, Hämaturie, Hämatemesis, ...?
Bei Anhaltspunkten für eine spezifische Ursache des Eisenmangels, die behandelbar ist, muss eine entsprechende gastroenterologische, urologische, gynäkologische, nephrologische oder onkologische Abklärung erfolgen.
Labordiagnostik
Eisenmangel ohne Anämie
Die Diagnose des Eisenmangels ohne Anämie wird durch die Bestimmung des Speicherproteins Ferritin im Serum gestellt. Der Ferritinspiegel (Ferritinwert) korreliert sehr gut mit dem Eisenvorrat im Körper und unterliegt im Gegensatz zum Eisen im Blut keinen Tagesschwankungen. Ein Eisenmangel ist die einzige Ursache für ein sehr tiefes Ferritin, was in einer ausgezeichneten Spezifität der Diagnostik resultiert, wenn nicht zusätzlich eine Entzündung oder Leberschädigung besteht (siehe unten).
Offizielle Grenzwerte, ab wann ein Eisenmangel besteht, gibt es zurzeit noch keine. Weitgehend Einigkeit besteht für folgende Aussagen:
- Ferritin < 15 µg/l: Eisenspeicher sind vollständig entleert
- Ferritin 15 - 30 µg/l: leere oder knappe Eisenspeicher
- Ferritin 30 - 50 µg/l: Grauzone, wo ein funktioneller Eisenmangel noch möglich ist. Hier muss der Arzt abklären, ob es typische Symptome gibt, die auf einen funktionellen Eisenmangel zurückzuführen sein könnten.
- Ferritin > 50 µg/l: Genügende Eisenreserve, wenn nicht gleichzeitig eine Entzündung (erhöhtes CRP) oder ein Leberschaden (erhöhte Transaminasen) vorliegen. Deshalb sollte man in diesen Fällen die Transferrinsättigung überprüfen.
Grenzwerte bei chronischen Erkrankungen:
- Bei chronischer Herzinsuffizienz: Ferritin < 100 µg/l oder Ferritin < 300 µg/l plus TSAT < 20%
- Bei chronisch-entzündlichen Darmerkrankungen (CED): Ferritin < 30 µg/l (ohne Entzündung) oder Ferritin < 100 µg/l plus TSAT < 20% (mit Entzündung)
- Bei chronischer Niereninsuffizienz (CKD): Ferritin < 200 µg/l plus TSAT < 25% (mit Entzündung)
- Bei Restless Legs Syndrom (RLS): Ferritin < 45 µg/l
Ferritin reagiert wie ein Akutphasenprotein und wird bei Entzündung und Leberzellschädigung vermehrt aus Makrophagen freigesetzt. Bei Entzündung besteht ausserdem eine Up-Regulation von Ferritin. In diesen Fällen ist das Ferritin im Serum kein verlässlicher Parameter für einen Eisenmangel. Dies ist der Grund, warum mit dem Ferritin zusammen immer das CRP und aufgrund der Freisetzung von Ferritin aus Hepatozyten auch die ALAT bestimmt werden sollten. Ist das CRP oder die ALAT erhöht, kann die Diagnose eines Eisenmangels schwierig werden. Neuere Studien lassen vermuten, dass die Messung des freien Transferrinrezeptors bei Patienten mit Entzündung und Verdacht auf Eisenmangel schlüssig sein könnte [1]. Diese Strategie ist aber noch zuwenig evaluiert, um im klinischen Alltag immer verlässlich angewendet werden zu können.
Weitere Befunde eines Eisenmangels sind Hypochromie und Mikrozytose im Blutbild. Vermindertes MCHC und MCV (Normalbereich 330-360g/l und 80-100fL) sind Ausdruck der eisenmangelbedingten Erythropoesestörung.
Die Knochenmarkaspiration mit Eisenfärbung des gewonnenen Materials galt lange als der Goldstandard für die Diagnose eines Eisenmangels. Aufgrund der Invasivität, der Schmerzhaftigkeit und des Aufwandes der Untersuchung kommt sie jedoch selten zum Einsatz. Zudem zeigt sich oft ein "sampling error", das heisst, das Resultat variiert je nach dem, ob gerade eine eisenreiche oder eisenarme Zone im Knochenmark getroffen wurde. Unter diesem "sampling error" leidet die Sensitivität der Untersuchung.
Im initialen Labor sollten bei Verdacht auf Eisenmangel also ein Blutbild inklusive Hb, das Ferritin, das CRP und die ALAT bestimmt werden.
Eisenmangelanämie
Die Eisenmangelanämie zeigt sich im roten Blutbild. Das erniedrigte Hb geht typischerweise mit einer hyporegenerativen Anämie, definiert durch eine Retikulozytenzahl < 50 G/l, einher. Mikrozytose und Hypochromie sind ausschlaggebend für die Diagnose einer Eisenmangelanämie. Weitere Merkmale des typischen Blutbildes sind:
- Anisozytose (unterschiedliche Grösse der Erys)
- Poikilozytose (unterschiedliche Form der Erys)
Leere Eisenspeicher - definiert durch ein sehr tiefes Ferritin - bestätigen die Diagnose der Eisenmangelanämie.
Referenzen
- Thomas C, Thomas L. Biochemical markers and hematologic indices in the diagnosis of functional iron deficiency. Clin Chem 2002;48:1066-1076





